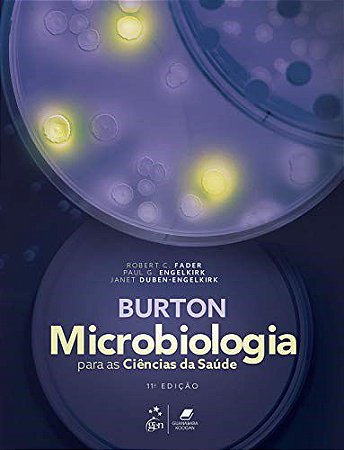
Livro Burton Microbiologia para as Ciências da Saúde

Livro Burton Microbiologia para as Ciências da Saúde
-
- 1x de R$ 292,00 sem juros
- 2x de R$ 146,00 sem juros
- 3x de R$ 97,33 sem juros
- 4x de R$ 73,00 sem juros
- 5x de R$ 58,40 sem juros
- 6x de R$ 48,66 sem juros
- 7x de R$ 41,71 sem juros
- 8x de R$ 36,50 sem juros
- 9x de R$ 32,44 sem juros
- 10x de R$ 29,20 sem juros
- 11x de R$ 26,54 sem juros
- 12x de R$ 24,33 sem juros
-
- 1x de R$ 292,00 sem juros
- 2x de R$ 146,00 sem juros
- 3x de R$ 97,33 sem juros
- 4x de R$ 73,00 sem juros
- 5x de R$ 58,40 sem juros
- 6x de R$ 48,66 sem juros
- 7x de R$ 41,71 sem juros
- 8x de R$ 36,50 sem juros
- 9x de R$ 32,44 sem juros
- 10x de R$ 29,20 sem juros
- 11x de R$ 26,54 sem juros
-
R$ 277,40

ISBN 9788527737081
Edição 11
Ano 2021
Idioma Português
Autor Fader
Páginas 512
Encadernação Brochura
Base sólida para o estudo da Microbiologia, Burton Microbiologia para as Ciências da Saúde apresenta conteúdo adequado a todos os cursos de introdução a essa disciplina, fornecendo informações cruciais para que os estudantes, no futuro, exerçam seu papel profissional de maneira orientada, segura e eficiente.Esta 11a edição, totalmente atualizada, contém novas informações acerca da importância domicrobioma humano na saúde e no desenvolvimento humanos, ampla cobertura das infecções relacionadas com a assistência à saúde causadas por microrganismos multirresistentes e o aparecimento de arbovírus, como chikungunya, dengue e Zika, nas Américas.
Sobre o Autor:
Robert C. Fader
PhD, D(ABMM)
Section Chief
Microbiology
Baylor Scott & White Health
Baylor Scott & White Medical Center – Temple
Temple, Texas
Paul G. Engelkirk
PhD, MT(ASCP), SM(NRCM)
Microbiology Consultant and Cofounder
Biomedical Educational Services (Biomed Ed)
Round Rock, Texas
Janet Duben-Engelkirk
EdD, MT(ASCP)
Biotechnology/Education Consultant and Cofounder
Biomedical Educational Services (Biomed Ed)
Round Rock, Texas
Revisão Técnica
Nathalie Henriques Silva Canedo
Graduação em Medicina pela Universidade Federal do Rio de Janeiro (UFRJ).
Doutorado em Ciência pelo Instituto de Biofísica Carlos Chagas Filho da UFRJ.
Residência em Patologia pela Universidade Federal Fluminense (UFF). Especialização em Patologia pela Associação Médica Brasileira. Professora Associada do Departamento de Patologia da Faculdade de Medicina da UFRJ.
Sumário:
Parte 1 Introdução à Microbiologia
Capítulo 1 Microbiologia
A Ciência
Capítulo 2 Visualização do Mundo Microbiano
Parte 2 Introdução aos Micróbios e Biologia Celular
Capítulo 3 Estrutura Celular e Taxonomia
Capítulo 4 Micróbios Acelulares e Procarióticos
Capítulo 5 Micróbios Eucarióticos
Parte 3 Aspectos Químicos e Genéticos dos Microrganismos
Capítulo 6 Base Bioquímica da Vida
Capítulo 7 Fisiologia e Genética Microbianas
Parte 4 Controle do Crescimento dos Micróbios
Capítulo 8 Controle do Crescimento dos Micróbios In Vitro
Capítulo 9 Uso de Agentes Antimicrobianos para Inibir o Crescimento de Patógenos In Vivo
Parte 5 Microbiologia Ambiental e Aplicada
Capítulo 10 Ecologia e Biotecnologia Microbianas
Capítulo 11 Epidemiologia e Saúde Pública
Parte 6 Microbiologia nos Serviços de Saúde
Capítulo 12 Epidemiologia na Área de Assistência à Saúde e Prevenção e Controle das Infecções
Capítulo 13 Diagnóstico das Doenças Infecciosas
Parte 7 Patogenia e Mecanismos de Defesa do Hospedeiro
Capítulo 14 Patogenia das Doenças Infecciosas
Capítulo 15 Mecanismos Inespecíficos de Defesa do Hospedeiro
Capítulo 16 Mecanismos Específicos de Defesa do Hospedeiro
Introdução à Imunologia
Parte 8 Principais Doenças Infecciosas Humanas
Capítulo 17 Visão Geral das Doenças Infecciosas nos Seres Humanos
Capítulo 18 Infecções Virais em Seres Humanos
Capítulo 19 Infecções Bacterianas em Seres Humanos
Capítulo 20 Infecções Fúngicas em Seres Humanos
Capítulo21 Infecções Parasitárias em Seres Humanos
Apêndices
A Respostas das Questões de Múltipla Escolha
B Respostas das Questões dos Estudos de Caso
C Conversões Úteis
D Alfabeto Grego
Glossário
Índice Alfabético
Produtos relacionados
-
 Livro Coaching com Pnl para Leigos - Burton
Livro Coaching com Pnl para Leigos - BurtonR$ 106,00R$ 84,80até 4x de R$ 21,20 sem jurosou R$ 80,56 via Boleto Bancário20% Desconto -
 Livro Programacao Neurolinguistica para Leigos - Burton /readyR$ 117,00até 5x de R$ 23,40 sem jurosou R$ 111,15 via Boleto Bancário
Livro Programacao Neurolinguistica para Leigos - Burton /readyR$ 117,00até 5x de R$ 23,40 sem jurosou R$ 111,15 via Boleto Bancário -
 Livro A Nova Ciência do Intestino Saúde Integral
Livro A Nova Ciência do Intestino Saúde IntegralR$ 98,00R$ 78,40até 3x de R$ 26,13 sem jurosou R$ 74,48 via Boleto Bancário20% Desconto -
 Livro Coaching com Pnl para Leigos - Edicao de Bolso - Burton
Livro Coaching com Pnl para Leigos - Edicao de Bolso - BurtonR$ 53,00R$ 42,40até 2x de R$ 21,20 sem jurosou R$ 40,28 via Boleto Bancário20% Desconto
-
Somos uma loja especializada em livros técnicos e didáticos voltados à área de saúde, direto, humanas, exatas.